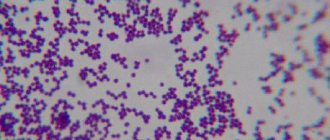

Индапамид является мочегонным средством, относится к классу тиазидные диуретики. Как правило используется для лечения артериальной гипертензии, а также сердечной недостаточности. Индапамид, как было доказано в HYVET, уменьшает смертность у пациентов старше 80 лет при лечении артериальной гипертензии.
Препарат доступен в дозировках 1,25 и 2,5 мг (миллиграмм) в виде таблеток. В настоящее время также существует форма SR (sustained release) с замедленным высвобождением.
Спиронолактон
Спиронолактон принадлежит к группе калийсберегающих мочегонных препаратов. Производится многими фармацевтическими предприятиями в виде таблеток, вид упаковки может меняться. Основное действующее вещество — также носит название спиронолактон.
Средство широко используется:
- для устранения отёчности у пациентов, страдающих от хронической сердечной недостаточности, цирроза печени, при беременности (во II и III триместре);
- при повышенной секреции альдостерона надпочечниками;
- гипертонической болезни;
- в терапии поликистоза яичников и предменструального синдрома.
Положительным свойством медикамента является то, что при выведении излишней жидкости из организма не происходит нарушение электролитного баланса плазмы крови. Спиронолактон мягкий диуретик, эффект после начала лечения проявляется спустя 2-5 дней.
Обладает рядом нежелательных побочных эффектов: гинекомастия, импотенция, гирсутизм, гиперкалиемия, нарушения менструального цикла.
Особые указания
Часто после стабилизации давления и при хорошем самочувствии пациенты перестают пользоваться лекарствами.
Это неправильное решение, доктора советуют принимать Индапамид постоянно.
Уменьшение дозировки, либо полное прекращение приема лекарства должно проводиться только под наблюдением врача.
Важный этап – регулярная сдача анализов крови на содержание креатинина, калия, прочих показателей, которые заинтересуют доктора.
В первую неделю приема Индапамида стоит оказаться от работы с опасными механизмами, управления автомобилем. Когда вы убедитесь, что лекарство не оказывает негативных действий, возвращайтесь к прежнему образу жизни. Препарат можно регулярно применять в течение шести-девяти месяцев, после чего обратиться к доктору за рекомендациями.
Верошпирон
Препарат Верошпирон фактически является аналогом Спиронолактона, так как содержит такое же действующее вещество по 25, 50 и 100 мг, в таблетках и желатиновых капсулах.
Основным отличием является только то, что Верошпирон всегда производится одной компанией GEDEON RICHTER, Plc. (Гедеон Рихтер) на заводах в Венгрии или России. Все перечисленные эффекты Спиронолактона относятся и к препарату Верошпирон.
Форма выпуска и дозировка
Оригинальное лекарство, содержащее индапамид, выпускает фармкомпания Сервье под торговой маркой Арифон. Помимо оригинального Арифона, в России зарегистрировано много дженериков с индапамидом, в том числе и под одноименным названием Индапамид. Аналоги Арифона производятся в виде капсул либо таблеток с пленочным покрытием. В последнее время популярны препараты с модифицированным высвобождением индапамида из таблетки.
В каких формах выпускается и сколько стоит Индапамид:
| Форма выпуска | Дозировка, мг | Производитель | Страна | Цена месяца лечения, руб. |
| Индапамид в таблетках | 2,5 | Пранафарм | Россия | от 18 |
| АлсиФарма | ||||
| Фармстандарт | ||||
| Биохимик | ||||
| ПромомедРус | ||||
| Озон | ||||
| Велфарм | ||||
| Авва-Рус | ||||
| Канонфарма | ||||
| Оболенское | ||||
| Валента | ||||
| Нижфарм | ||||
| Тева | Израиль | 83 | ||
| Хемофарм | Сербия | 85 | ||
| Индапамид в капсулах | 2,5 | Озон | Россия | от 22 |
| Вертекс | ||||
| Тева | Израиль | 106 | ||
| Индапамид длительного действия в таблетках | 1,5 | ПромомедРус | Россия | от 93 |
| Биохимик | ||||
| Изварино | ||||
| Канонфарма | ||||
| Татхимфармпрепараты | ||||
| Оболенское | ||||
| АлсиФарма | ||||
| Нижфарм | ||||
| КРКА-Рус | ||||
| МакизФарма | ||||
| Озон | ||||
| Хемофарм | Сербия | 96 | ||
| Гедеон Рихтер | Венгрия | 67 | ||
| Тева | Израиль | 115 |
По отзывам кардиологов, обычный Индапамид предпочтительно покупать в капсулах. Лекарство в капсулах дольше хранится, имеет более высокую биодоступность, быстрее всасывается, содержит меньше вспомогательных компонентов, а значит, реже вызывает аллергию.
Наиболее современной формой Индапамида являются таблетки длительного действия. Действующее вещество из них высвобождается медленнее благодаря особой технологии: небольшие количества индапамида равномерно распределены в целлюлозе. Попав в ЖКТ, целлюлоза понемногу превращается в гель. На растворение таблетки требуется около 16 часов.
По сравнению с обычными таблетками, Индапамид длительного действия дает более стабильный и сильный гипотензивный эффект, суточные колебания давления при его приеме меньше. По силе действия 2,5 мг обычного Индапамида равны 1,5 мг длительного. Большинство побочных действий являются дозозависимыми, то есть их частота и выраженность увеличивается при увеличении дозы. Прием продленных таблеток Индапамид позволяет снизить риск побочек, в первую очередь падения уровня калия крови.
Отличить продленный Индапамид можно по дозировке 1,5 мг. На упаковке должно быть указание «пролонгированного действия», «модифицированного высвобождения», «контролируемого высвобождения», в названии могут содержаться «ретард», «МВ», «лонг», «SR», «СР».
Инспра
Инспра – это также калийсберегающий диуретик. Препарат эффективно выводит излишнюю жидкость, убирает отёки, предотвращая при этом потерю нужного для полноценной и правильной работы сердечной мышцы микроэлемента – калия.
Выпускается Инспра в виде таблеток компанией PFIZER, Inc. (Пфайзер), США. Действующее вещество — эплеренон с содержанием в пилюлях по 25 мг. Создан позже спиронолактона и обладает меньшим числом побочных эффектов. При длительной терапии Инспра у пациентов с хронической коронарной недостаточностью развивается меньше побочных эффектов. Практически не вызывает гинекомастии, гирсутизма, импотенции. Коррекции дозы не требуется, что важно для терапии людям с сахарным диабетом, пожилым и со сниженной функцией почек.
Возможные побочные действия
Лекарство Индапамид может вызывать нежелательные эффекты при его использовании. Отклонения обычно касаются таких систем:
- нервная (центральная и периферическая часть);
- сердечно-сосудистая;
- дыхательная;
- пищеварительная;
- мочевыделительная.
Больной может отмечать головокружение, у некоторых людей нарушается сон, появляется депрессия, апатия и сонливость, наблюдается астенический синдром. Иногда отмечается выраженная раздражительность, возбудимость, постоянное чувство переутомления. Зафиксированы также нарушения периферической чувствительности и спазмы мышц конечностей.
Со стороны сердца может развиваться нарушение ритма, появляются изменения на кардиограмме, снижение калия в крови приводит к изменениям в проводящей системе сердечной мышцы. У пациента может наблюдаться сильное снижение давления при переходе из горизонтального положения в вертикальное.
Нарушения в работе верхних дыхательных путей проявляются кашлем, насморком, воспалением глотки, бронхоспазмом.
Таблетки Индапамид могут иногда вызывать ухудшение аппетита, ощущение сухости в полости рта, тошноту и рвоту. Реже появляются боли и рези в животе, нарушение стула (диарея или запор). Изредка отмечается обострение панкреатита. Если у человека, принимающего препарат, серьезные проблемы с печенью, то на фоне терапии возможно появление признаков печеночной энцефалопатии.
В почках и нижележащих мочевыводящих путях на фоне использования этого мочегонного средства может поселиться инфекция. Иногда у больного отмечается увеличение выведения мочи в ночное время (никтурия) или полиурия.
Может нарушиться работа системы кроветворения: обычно возникает снижение тромбоцитов и лейкоцитов в крови, развивается агранулоцитоз, увеличивается вероятность кровотечений, снижается время свертывания. Не исключены также анемия гемолитического характера, аплазия костного мозга.
Непереносимость компонентов, входящих в состав препарата, может сопровождаться аллергическими проявлениями. Обычно отмечают крапивницу, зуд и жжение кожи, сыпь в виде папул или пятен.
При курсовом приеме Индапамида меняется минеральный состав крови. Повышается уровень кальция, а также глюкозы в плазме, гиперурикемия, снижается уровень хлорида натрия. При нарушении работы почек может повышаться мочевина, креатинин. Поэтому уровень указанных соединений нужно постоянно проверять.
Обычно побочные действия проявляются нечасто, но если они возникли, рекомендуется сразу прекратить прием препарата и обратиться к врачу для корректировки лечения.
Гипотиазид
Гипотиазид – тиазидный мочегонный препарат первого поколения, обладающий умеренным диуретическим и антигипертензивным действием. Активное вещество гидрохлортиазид. Используются как в монотерапии, так и в комбинациях с препаратами других фармакологических групп. Усиливает выведение из организма с мочой ионов калия, магния, гидрокарбонатов и фосфатов. Задерживает ионы кальция и ураты.
После перорального приёма эффект от лекарственного средства наступает очень быстро, в течение получаса, длится в течение 6-14 часов. Мягкое воздействие Гипотиазида используют для терапии следующих недугов:
- гипертонии;
- хронических отёках;
- несахарном диабете;
- для профилактики камнеобразования в мочевыводящих органах у пациентов с гиперкальциурией.
Гипотиазид можно принимать длительное время, но при этом следует периодически контролировать уровень электролитов лабораторными исследованиями крови.
Вызывает также в значительной степени следующие негативные метаболические побочные эффекты:
- увеличивает уровень холестерина, липопротеидов низкой и очень низкой плотности, триглицеридов;
- снижает толерантность к глюкозе;
- усиливает гиперурикемию.
Поэтому некоторые врачи отдают предпочтение Индапамиду, как более совершенному препарату.
Главная информация
- У Вас возникли вопросы про индапамид? Поговорите с Вашим доктором.
- Индапамид должен использоваться только тем человеком, которому он прописан. Не делитесь препаратом с другими людьми!
- Если симптомы Вашего заболевания не улучшаются, а только становятся хуже – поговорите с Вашим доктором.
Эта информация не должна использоваться для решения следует ли принимать данный препарат или любые другие лекарственные средства. Только Ваш лечащий врач имеет определенные знания и навыки, чтобы решить, какие именно лекарства Вам подходят. Эта информация не выдвигает какие-либо препараты как безопасные, эффективные и так далее. Это лишь краткая общая информация об индапамиде. Она не включает всю информацию о возможных способах использования, мер предосторожности, взаимодействий, побочных эффектов или рисков, которые могут появляться при применении индапамида. Эта информация не является консультацией и не заменяет информацию, которую Вы получаете от Вашего лечащего врача. Вы должны поговорить со своим доктором для получения полной информации о рисках и преимущества использования индапамида.
Индапамид
Индапамид содержит одноименное активное вещество. Относится к группе – тиазидных диуретиков. Обладает умеренным мочегонным эффектом, выводит натрий из организма, мало влияет на уровень калия и мочевой кислоты. Вызывает снижение периферического сосудистого сопротивления и кровяного давления. Преимущество лекарства заключается в сохранении эффекта индапамида в ранние часы, когда риск сердечно-сосудистых осложнений особенно высок.
После приема таблетки мочегонный эффект наступает в течение часа и сохраняется до 12-18 ч. В таблетках с замедленным высвобождением активного компонента (Индапамид ретард) действие длится до 24 ч. Прием пролонгированной формы способствует уменьшению гипертрофии левого желудочка сердца. Не влияет на углеводный и липидный обмен даже у пациентов с сахарным диабетом.
Обычно препарат назначается 1-2 раза в день, в утренние часы при артериальной гипертензии, сердечных отеках. Стойкий терапевтический эффект достигается непрерывным приемом медикамента не менее 3 месяцев.
Чем отличаются
Разница между представленными лекарственными средствами в следующем:
- «Индапамид» отличается более мягким и щадящим воздействием на организм.
- «Фуросемид» обладает обширным списком противопоказаний и «побочек». И проявляются побочные эффекты более ярко, и чаще, чем у второго медикамента.
- В силу мощности диуретического эффекта «Фуросемид» применяют по необходимости. Для второго медсредства предусмотрен курсовой прием. Причем некоторые пациенты используют его в течение нескольких лет.
- Несмотря на мягкость и относительную безопасность «Индапамида» беременным женщинам и лицам, моложе 18-лет принимать его запрещено. Другой препарат может назначаться в случае крайней необходимости как беременным, так и детям.
- «Фуросемид» имеет как твердую (таблетки), так и жидкую (раствор) формы выпуска. Второе средство выпускается только в пилюлях.
- Отличаются препараты также химическим составом. Имеют различные активные компоненты.
Разница в ценах, хоть и не критичная, тоже присутствует. «Индапамид», в зависимости от производителя, стоит в аптеках от 16 до 110 руб. «Фуросемид» любого формата выпуска – от 19 до 23 руб.
Фуросемид
Препарат Фуросемид является не только самым распространённым и популярным среди диуретиков, но и самым сильным. Относится к группе петлевых диуретиков. Выпускается в виде таблеток и раствора для инъекций.
Лекарственное средство очень быстро выводит излишнюю жидкость, а также соли натрия. Препарат способствует быстрому снижению кровяного давления, устраняет отёчность, спровоцированную различными патологиями печени, сердца и почек. В неотложной терапии инъекция Фуросемида требуется при отеке мозга, легких, гипертоническом кризе.
Одноименное активное вещество (фуросемид) после приема внутрь таблетки Фуросемид начинает действовать через 30-60 мин, после инъекции — спустя 5-10 мин. Длительность эффекта — 2-3 часа. При использовании препарата 1 раз в сутки существенного антигипертензивного действия не наблюдается.
Достоинства Фуросемида:
- очень сильный мочегонный эффект;
- эффективен при сильных отёках.
Недостатки заключаются в большом перечне побочных явлений и противопоказаний. Длительное использование препарата может привести к обезвоживанию организма, нарушению электролитного баланса плазмы крови. Это гипокалиемия, приводящая к мышечной слабости, анорексии, запорам и нарушениям сердечного ритма. Также Фуросемид увеличивает выведение из организма кальция и магния, но повышает уровень мочевой кислоты.
Рекомендуется использовать препарат только по назначению врача. С особой осторожностью принимать при заболеваниях почек.
Взаимодействие с другими лекарственными средствами
Человек нередко вынужден принимать несколько препаратов, принадлежащих к разным лекарственным группам. Их активные вещества могут снижать либо усиливать эффективность Индапамида. Стоит остановиться подробнее на том, как такие “взаимодействия” проявляются.
Гипотензивный эффект лекарства повышается при употреблении вместе с антидепрессантами, нейролептиками — это способно вызвать резкое падение давления.
При сочетании с Эритромицином у человека возникает тахикардия, в комплексе Циклоспорином — повышается уровень креатинина. Одновременное применение вместе с препаратами, в состав которых входит йод, может спровоцировать обезвоживание организма. Потере калия способствуют слабительные средства, салуретики и сердечные гликозиды.
Следует учитывать, что кортикостероиды и НПВП (нестероидные противовоспалительные препараты) снижают гипотензивное действие Индапамида — это уменьшает эффективность средства. Чтобы избежать подобного взаимодействия с другими лекарствами, врачу нужно предоставить перечень всех употребляемых медикаментов и фитопрепаратов.
Торасемид
Лекарственное средство Торасемид принадлежит к группе петлевых диуретиков, как и фуросемид, но является лекарством нового поколения. Имеет ряд принципиальных отличий от фуросемида:
- имеет более выраженный диуретический и натрийуретический эффект;
- в меньшей степени выводит калий;
- антигипертензивное действие не основано на уменьшении объема циркулирующей крови, а вызвано расширением сосудов, устранением ангиоспазма.
Эти свойства позволяют использовать Торасемид у пациентов с артериальной гипертензией. Пролонгированная форма может быть комбинирована в терапии с антикоагулянтами, сердечными гликозидами, нитроглицерином и блокаторами кальциевых каналов. Одновременное использование с калийсберегающими диуретиками предотвращает электролитные нарушения в организме.
Действие лекарства начинается через час после его приёма. Максимальный эффект от Торасемида наступает через 2 часа и держится от 12 до 18 часов.
, а также при неправильном использовании может вызвать развитие состояния передозировки и
.
Передозировка
Случаи передозировки очень редки. Токсичная доза 40 мг, нарушает водно-солевой баланс в организме. Потом возникают такие симптомы:
- чувство сухости во рту и жажды;
- гипотензия;
- олигурия/полиурия;
- слабость и тошнота/рвота;
- головокружение;
- сонливость;
- боль в мышцах.
Если появились такие симптомы после приема Индапамида, надо вызвать скорую помощь, промыть желудок, принять энтеросорбент — активированный уголь. Чтобы восстановить водный баланс пить побольше жидкости.
Источники
- Спиронолактон (Spironolactone) https://www.vidal.ru/drugs/spironolactone-2
- Верошпирон (Verospiron) инструкция по применению https://www.vidal.ru/drugs/verospiron__149
- Инспра® (Inspra) инструкция по применению https://www.vidal.ru/drugs/inspra__42133
- Верошпилактон (Verospilactone) инструкция по применению https://www.vidal.ru/drugs/verospilactone__41964
- Индапамид (Indapamide) https://www.vidal.ru/drugs/indapamide__39560
- Фуросемид (Furosemide) https://www.vidal.ru/drugs/furosemide__23309
- Торасемид (Torasemide) https://www.vidal.ru/drugs/torasemide-3
- Диувер (Diuver) инструкция по применению https://www.vidal.ru/drugs/diuver__8865
- Гипотиазид® (Hypothiazid®) инструкция по применению https://www.vidal.ru/drugs/hypothiazid__1739
- Т.Е.Морозова, И.Ю.Юдина. Выбор диуретических лекарственных средств для лечения артериальной гипертензии в амбулаторно-поликлинической практике. Журнал Справочник поликлинического врача. 2017; 03: 38-42
Поделиться:
Аналоги и заменители
Полностью повторяют препарат по составу и дозировке, то есть являются полными аналогами Индапамида, следующие зарегистрированные в РФ лекарства:
| Название | Форма | Производитель | Цена за 30 шт., руб. | |
| обычная | ретард | |||
| Арифон/Арифон Ретард | табл. | табл. | Сервье, Франция | 345/335 |
| Индап | капс. | — | ПроМедЦс, Чехия | 95 |
| СР-Индамед | — | табл. | ЭджФарма, Индия | 120 |
| Равел СР | — | табл. | КРКА, РФ | 190 |
| Лорвас СР | — | табл. | Торрент Фармасьютикал, Индия | 130 |
| Ионик/Ионик ретард | капс. | табл. | Оболенское, РФ | в аптеках отсутствуют |
| Тензар | капс. | — | Озон, РФ | |
| Индипам | табл. | — | Балканфарма, Болгария | |
| Индиур | табл. | — | Польфа, Польша | |
| Акутер-Сановель | — | табл. | Сановель, Турция | |
| Ретапрес | — | табл. | Биофарм, Индия | |
| Ипрес Лонг | — | табл. | ШварцФарма, Польша | |
Ими можно заменить Индапамид без дополнительной консультации лечащего врача. По отзывам пациентов, принимавших препараты, самыми качественными из данного перечня являются таблетки Арифон и Индап.
Фармакокинетика
После перорального приема препарат полностью и быстро всасывается из желудочно-кишечного тракта. Лекарственное средство обладает высокой биодоступностью — 93%. Прием пищи незначительно замедляет скорость абсорбции, но количество всосавшегося лекарства остается стабильным. Максимальная концентрация препарата в плазме крови достигается через 1-2 ч после перорального приема. При регулярном приеме индапамида его концентрация в крови стабилизируется 7-9 дню применения. Период полураспада лекарственного средства составляет в среднем 18 часов. Препарат связываться с протеинами плазмы крови на 79%. Фармакологическое средство также связывается с эластином миоцитов стенок сосудов. Метаболизм лекарственного средства происходит в печени. Почками препарата экскретируется на 70% преимущественно в виде метаболитов, а через кишечник – 20-30%. Фармакокинетика препарата при почечной недостаточности не меняется. Не обладает кумулятивным эффектом.
Противопоказания
Лекарственное средство имеет такие противопоказания:
- расстройства функционирования печени выраженные;
- индивидуальная непереносимость компонентов;
- хроническая почечная недостаточность;
- наличие подагры;
- декомпенсированная стадия диабета;
- дефицит в крови калия или азота;
- до 18 лет;
- острое нарушение кровообращения, возникшее в головном мозге;
- беременность и грудное вскармливание.
Крайне нежелательно принимать препарат вместе с алкоголем. Также в период соревнований профессиональным спортсменам стоит от него отказаться при допинг-контроле, поскольку он вызывает положительный результат пробы.